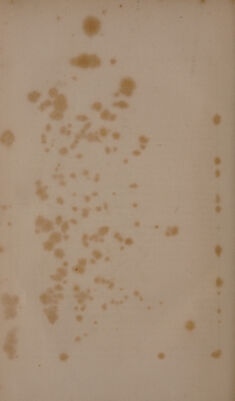

Copy 1, Volume 1
Letters and notes on the manners, customs, and condition of the North American Indians. By Geo. Catlin. Written during eight years' travel amongst the wildest tribes of Indians in North America, in 1832, 33, 34, 35, 36, 37, 38 and 39... With four hundred illustrations, carefully engraved from his original paintings / [George Catlin].
- George Catlin
- Date:
- 1844
Licence: Public Domain Mark
Credit: Letters and notes on the manners, customs, and condition of the North American Indians. By Geo. Catlin. Written during eight years' travel amongst the wildest tribes of Indians in North America, in 1832, 33, 34, 35, 36, 37, 38 and 39... With four hundred illustrations, carefully engraved from his original paintings / [George Catlin]. Source: Wellcome Collection.
1/432